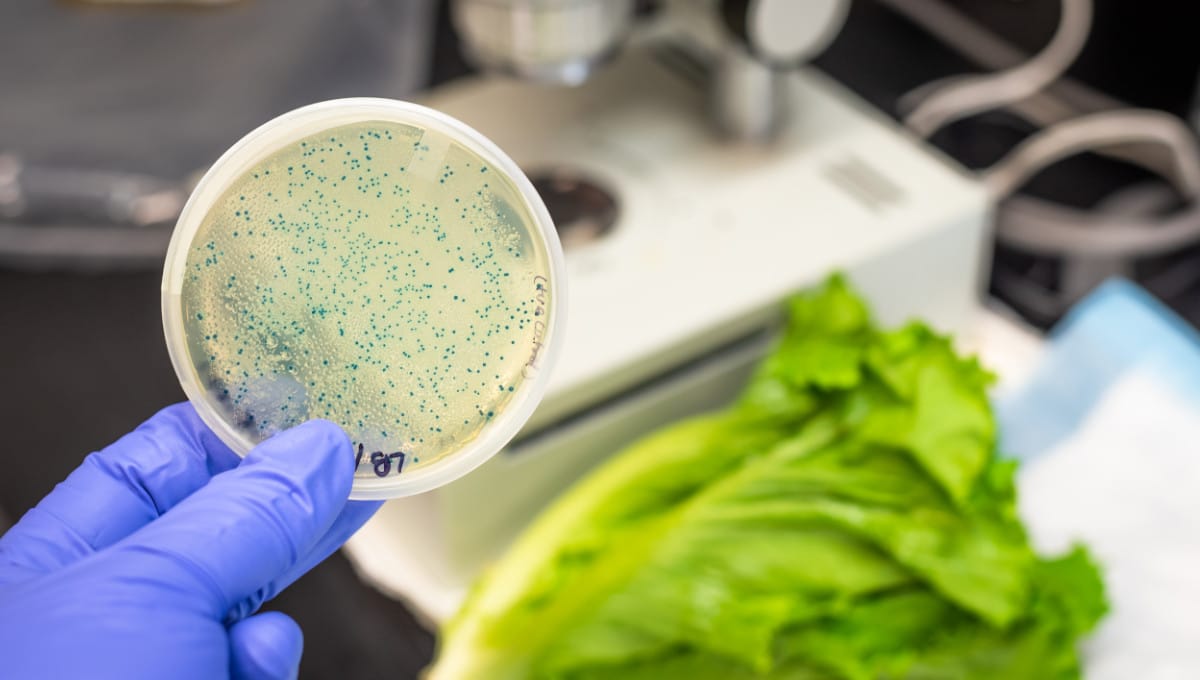
www.foodsafetynews.com

Yes, it was "Dr Deer" Kroll.Was it Dr. Kroll? Sounds like it was transforming it to mirror Texas MLD program. From the private landowner side the MLD program is probably the most ecological friendly program backed by sound science in the US. Although in some parts you better be prepared to kill a lot of deer to provide relief to the eco system
Navigation
Install the app
How to install the app on iOS
Follow along with the video below to see how to install our site as a web app on your home screen.
Note: This feature may not be available in some browsers.
More options
Style variation
You are using an out of date browser. It may not display this or other websites correctly.
You should upgrade or use an alternative browser.
You should upgrade or use an alternative browser.
Is CWD Politically Generated ?
- Thread starter cnelk
- Start date
cuerro viejo
WKR
- Joined
- Apr 1, 2013
- Messages
- 3,825
Then he was pushing for more of a MLD type program. Guy knows his deer ecology.Yes, it was "Dr Deer" Kroll.
MLD is Program where tags are based off population counts in regards to carrying capacity and herd ratios, you can use private biologists or state. Lots of a fun work that goes into it including browse studies etc.
Pacific_Fork
Well Known Rokslider
No, go talk to one of the many biologist who hunt. It’s definitely real.
- Banned
- #65
Whitey Fisk 88
FNG
- Joined
- Dec 17, 2022
- Messages
- 61
Finally someone gets it: captive deer herds started it and the sale and transportation of captive deer have spread it exponentially faster. But its still 100% legal...Not sure if it's politically generated in PA, but dealing with it sure is. Our first case in PA was in 2012 and traced to a captive herd in a deer farm. Every case since then can be traced back to another damn deer farm. Probelm. Pennsylvania Game Commission has zero authority over game farms. That falls under the auspice of PA Dept of Agriculture. And they have zero interest in shutting down the deer farms. The really ironic thing? Deer waste, feces, urine, salivia, is thought to be a vector for CWD transmission. In PA's DMA's or disease management areas, it's illegal to use deer urine based lures. Even though there are deer lure operations operating within those restricted areas. That's right. Gathering deer urine from a deer farm in an area with high CWD cases for resale in other areas.
You hunters better boil your skull cap before bringing county to county though!!!
Deer farming is a big money industry with a big lobby group. Until we stop them or at least get heavy regulations then the problem will only continue to get worse.
justin davis
WKR
In my opinion CWD isn’t an issue. So it doesn’t make sense to me to kill off all the deer to stop something that isn’t an issue. I think EHD is worse but it doesn’t seem to concern them. But that’s my opinion
Reburn
Mayhem Contributor
Finally someone gets it: captive deer herds started it and the sale and transportation of captive deer have spread it exponentially faster. But its still 100% legal...
You hunters better boil your skull cap before bringing county to county though!!!
Deer farming is a big money industry with a big lobby group. Until we stop them or at least get heavy regulations then the problem will only continue to get worse.
Tell us where CWD started again. Where was it first discovered? Was there any captive deer at that time?
- Banned
- #68
Whitey Fisk 88
FNG
- Joined
- Dec 17, 2022
- Messages
- 61
In deer it was first discovered in a captive mule deer in Colorado State University pens....i think that answers questions both 1 and 2Tell us where CWD started again. Where was it first discovered? Was there any captive deer at that time?
wind gypsy
"DADDY"
- Joined
- Dec 30, 2014
- Messages
- 13,358
I've not done many hours of critical research but with the delayed impact of Creutzfeldt-jakob disease in humans from mad cow, and possible misdiagnosis as alzheimer's, I'm not eager to eat or feed my family any meat from a CWD infected deer. If the prions stay on the landscape for years, it seems like minimizing the spread and quantity of that is a reasonable goal.
If it's proven to ever jump to humans or livestock big game hunting and game populations are in big trouble. Way more so than it is with aggressive quotas and season structures targeting mature deer. I'd sure hate to see it get to that and know that I got in the way of anything being done because I wanted more big bucks around to shoot.
Sucky part is it doesn't seem like killing a bunch more deer and testing is really doing much right now to tell us anything. If it results in more areas that aren't heavily infected before we can learn more, i think that's a compromise i'm willing to make.
It seems like @Reburn has some info about possible scrapies being misdiagnosed as CWD? Any links on that?
If it's proven to ever jump to humans or livestock big game hunting and game populations are in big trouble. Way more so than it is with aggressive quotas and season structures targeting mature deer. I'd sure hate to see it get to that and know that I got in the way of anything being done because I wanted more big bucks around to shoot.
Sucky part is it doesn't seem like killing a bunch more deer and testing is really doing much right now to tell us anything. If it results in more areas that aren't heavily infected before we can learn more, i think that's a compromise i'm willing to make.
It seems like @Reburn has some info about possible scrapies being misdiagnosed as CWD? Any links on that?
MTSasquatch
WKR
- Joined
- Jul 21, 2019
- Messages
- 527
Simple thought exercise for your answer:
1) The potential human health outcomes of CWD remains a possibility and is concerning.
2) It’s 2022, so everything is political.
But simply because both 1 and 2 are real does not make CWD political. We need not always conflate issues with politics.
1) The potential human health outcomes of CWD remains a possibility and is concerning.
2) It’s 2022, so everything is political.
But simply because both 1 and 2 are real does not make CWD political. We need not always conflate issues with politics.
Reburn
Mayhem Contributor
In deer it was first discovered in a captive mule deer in Colorado State University pens....i think that answers questions both 1 and 2
So the deer was born in the pen or it was aquired out of the wild?
Your so very wrong but hey, thats ok. some people struggle with facts and timelines. Especially with first detected in vs started in.
Please show the trace forward from a mule deer in a state facility in CO and then to a mule deer in toronto and then to a wild elk in canada.

It seems like @Reburn has some info about possible scrapies being misdiagnosed as CWD? Any links on that?
Short answer is the current proposed orgin is the prion jumped from sheep or goats to deer. I dont have links as it was paper not digital and I didnt save it. I tend to not put alot of stock into scientific papers until they have been peer reviewed at least a couple times and becomes gernerally accepted as fact. However goats, sheep and deer are very similar on an number of levels biologically so the hypothesis at least holds water pass the inital sniff test.
- Banned
- #72
Whitey Fisk 88
FNG
- Joined
- Dec 17, 2022
- Messages
- 61
So if i take a wild animal, put it in the zoo, then its still wild by your logic ??So the deer was born in the pen or it was aquired out of the wild?
Your so very wrong but hey, thats ok. some people struggle with facts and timelines. Especially with first detected in vs started in.
Please show the trace forward from a mule deer in a state facility in CO and then to a mule deer in toronto and then to a wild elk in canada.

Short answer is the current proposed orgin is the prion jumped from sheep or goats to deer. I dont have links as it was paper not digital and I didnt save it. I tend to not put alot of stock into scientific papers until they have been peer reviewed at least a couple times and becomes gernerally accepted as fact. However goats, sheep and deer are very similar on an number of levels biologically so the hypothesis at least holds water pass the inital sniff test.
Where the deer was born isnt the action thats causing the issues , its the human intervention of putting them in a pen where theyre being fed, bred, transported and living ass to ass with other deer that is wholly unantural. How can you not grasp that??
Im starting to think this is Keith Warren's or Mark Drurys account lol.
Reburn
Mayhem Contributor
So if i take a wild animal, put it in the zoo, then its still wild by your logic ??
Where the deer was born isnt the action thats causing the issues , its the human intervention of putting them in a pen where theyre being fed, bred, transported and living ass to ass with other deer that is wholly unantural. How can you not grasp that??
Im starting to think this is Keith Warren's or Mark Drurys account lol.
If you take a wild animal and cage it, its a wild animal caged not a domestic animal.
first generation born in captivity would be domestic argumentatively.
The disease didnt come from being caged or poor living conditions. it came from the wild into the pen with the deer. How can you not grasp that??
Im beginning to think this is josh bomars secret account lol.
Billy Goat
“MOMMY”
If you take a wild animal and cage it, its a wild animal caged not a domestic animal.
first generation born in captivity would be domestic argumentatively.
The disease didnt come from being caged or poor living conditions. it came from the wild into the pen with the deer. How can you not grasp that??
Im beginning to think this is josh bomars secret account lol.
Easy on the Bromar stuff, he doesn't cage them.
Just turns them loose on his new primo farms.
cuerro viejo
WKR
- Joined
- Apr 1, 2013
- Messages
- 3,825
First observed. Big difference. How long have sheep been roaming the hill if the US? When was the last Scrapies out break?In deer it was first discovered in a captive mule deer in Colorado State University pens....i think that answers questions both 1 and 2
Always more to it. Breeders helped move it around but that’s not to say it’s all their fault. Several states that didn’t get it from breeders, it walked across or popped up…. Maybe not so randomly.
CWD: chronic worrying disease
Hell yes it's political. There is money involved and no one is "controlling" anything
Based on historical data I would get your salad tested before your backstrap

 www.foodsafetynews.com
www.foodsafetynews.com
Hell yes it's political. There is money involved and no one is "controlling" anything
Based on historical data I would get your salad tested before your backstrap
FDA says E. coli outbreak associated with romaine lettuce is over
Federal officials are reporting that an outbreak of E. coli O121:H9 infections linked to romaine lettuce has ended. Four illnesses were confirmed in the
Backyard
WKR
I can see how it could be. Here in Minnesota if they get a single CWD positive deer in an area they decide to decimate the deer herd and in the end you still have CWD and a lot less deer.
Sent from my SM-G991U using Tapatalk
When and where did the MNDNR ever decimate an entire wild herd?
Sent from my iPhone using Tapatalk
Backyard
WKR
I can see how it could be. Here in Minnesota if they get a single CWD positive deer in an area they decide to decimate the deer herd and in the end you still have CWD and a lot less deer.
Sent from my SM-G991U using Tapatalk
When and where did the MNDNR ever decimate an entire wild herd?
Sent from my iPhone using Tapatalk
maddmartagan
Lil-Rokslider
- Joined
- May 29, 2016
- Messages
- 147
Yes it is…but only because morons like OP ask questions like this…
Sent from my iPhone using Tapatalk
Sent from my iPhone using Tapatalk
Nickofthewoods
WKR
Yes it is…but only because morons like OP ask questions like this…
Sent from my iPhone using Tapatalk
Why are you so mad maddmartagan? Most of your posts are really angry.
Jesus Christ there are some loons on this forum
Sent from my iPhone using Tapatalk
Maybe time for you to find a new forum with less loons?
Similar threads
- Replies
- 103
- Views
- 7K
- Replies
- 130
- Views
- 6K
Featured Video
Latest Articles
- What the Mule Deer Conservation Strategy Reveals About Wyoming’s Future
- West-wide Snowpack & Precipitation Update with Josh Boyd
- Leica PRS 5-30x56i Field Review
- Backcountry Mule Deer Hunting with Braxton Hamilton & Storie Ratcliff
- The Next Level in Optics with Ryan Holm of Leica
- Teratorn Backpack Review
- Argali Serac MagnaCut Knife Review
- James Yates: Leveraging Data for Archery Excellence
- How Old Was He Really? Big Buck Hunters Talk Age vs. Score
- Banning Hunting Technology in Idaho?

